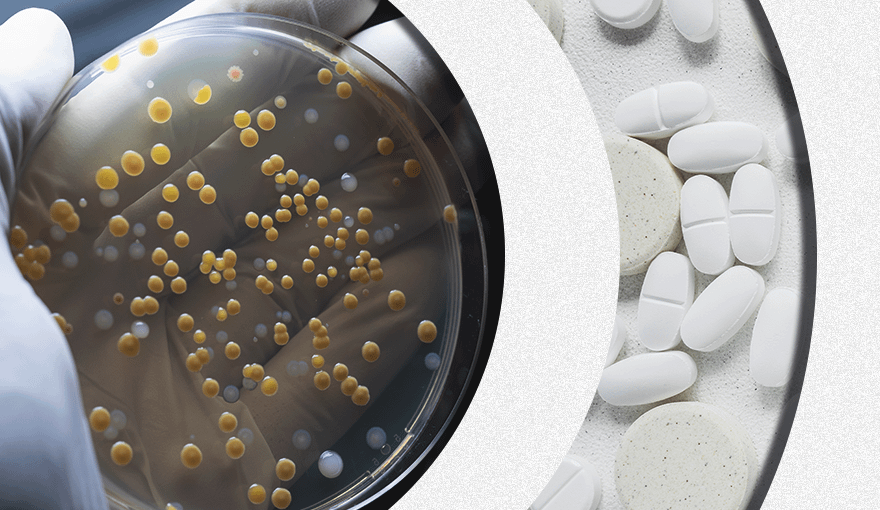

1. Затонувший корабль «Эндьюранс»
Корабль «Эндьюранс» совершал экспедицию в Антарктиду в 1915 году. Он потерпел крушение в море Уэдделла, которое находится между Антарктическим полуостровом и Землей Котса. К счастью, команде из 28 человек удалось выжить. Но точное место, где затонул корабль, оставалось неизвестным до 2022 года.
Условия и местность, в которой произошло крушение, значительно затрудняли поиски «Эндьюранса». Плотно покрытые льдом воды моря не позволяли применять классические методы обнаружения затонувших судов. Но экипаж спасательной экспедиции под названием Endurance22 применил новые технологии и отыскал корабль. Это удалось осуществить с помощью автономных подводных роботов Sabertooths. На них были установлены лазерные сканеры и гидролокаторы, а также камеры, которые позволяли наблюдать за ходом поисков в реальном времени.
Когда обломки корабля были найдены, роботы использовали сканирующие устройства и создали 3D-модель затонувшего судна и близлежащих обломков.
2. Алмазная пыль на поверхности Меркурия
Поверхность наименьшей планеты Солнечной системы, как оказалось, покрыта алмазной пылью. Об этом открытии в 2022 году объявил Кевин Кэннон, изучающий планетарные науки и геологию в Брауновском университете США.
Моделирование поверхности Меркурия за последние четыре миллиарда лет показало, что в начале своего формирования планета была покрыта магматическим океаном. Внутри магмы образовался графит, который со временем образовал корку, поднявшись на поверхность. Ее толщина, по предварительным оценкам, составляла несколько сотен метров.
После образования Солнечной системы Меркурий постоянно сталкивался с астероидами. Это и могло привести к тому, что графит преобразовался в алмазы.
Но ученые отмечают, что они не похожи на камни, которые люди привыкли видеть в украшениях. Они представляют собой микроскопическую пыль. Но ее количество, по оценкам ученых, в 16 раз превышает запасы алмазов Земли.
3. Механизм сопротивления бактерий антибиотикам
В 2022 году в журнале Molecular Cell была опубликована научная статья, которая объясняла новый механизм сопротивления бактерий антибиотикам. Исследование под руководством доктора Джерри Райта было проведено в Университете Макмастера, Канада.
Лабораторный эксперимент определил сложный механизм, который используют бактерии, чтобы защититься от антибиотиков класса рифамицина. Они встречаются в природе, а также воспроизводятся искусственно и входят в состав средств для лечения инфекционных заболеваний.
Действие рифамицинов заключается в связи с РНК-полимеразой — белком, который необходим для жизни бактерий. Но они, в свою очередь, выработали специально адаптированные белки, которые помогают вытеснить рифамицин из РНК, а затем атаковать и уничтожить его.
Теперь доктор Райт и его коллеги анализируют другие образцы бактерий, чтобы понять, насколько распространен этот механизм. Их исследования помогут улучшить эффективность лекарственных средств и разработать новые.
4. Структура состава, использовавшегося для покрытия инструментов Страдивари
Скрипки, альты и виолончели Антонио Страдивари считаются одними из лучших в мире. Они позволяют извлекать звук исключительной чистоты.
В 2022 году итальянские ученые изучали нанометровые изображения скрипок Страдивари и обнаружили, что между слоем дерева и лака при их изготовлении применялся неизвестный состав. Он заполнил и сгладил древесину, что повлияло как на резонанс, так и на звук инструментов.
Чтобы понять состав покрытия скрипок, ученые обратились к сканирующей микроскопии ближнего поля с инфракрасным рассеянием. Для этого они использовали аппарат IR s-SNOM. Он представляет собой микроскоп, который собирает изображения шириной в десятки нанометров и измеряет инфракрасный свет, рассеянный от слоя покрытия и древесины.
Результат показал, что ранее неизвестный состав скрипок содержит соединения на основе белка. Они собираются в наноразмерные пятна, поэтому их различил микроскоп.
Теперь ученым предстоит выяснить точный состав средства, которое применялось при покрытии инструментов. Для этого они будут использовать полученную трехмерную картину типов веществ.
5. Искусственный интеллект, способный реагировать на окружающую среду
Команда австралийских ученых под руководством доктора Бретта Кагана создали искусственный интеллект, способный распознавать сигналы из окружающей среды и отвечать на них. Подробный отчет о разработке и исследованиях был опубликован в журнале Neuron.
Ученые назвали свое устройство «разумный мозг». И даже научили играть его в Pong. Это простая игра, разработанная в 1972 году. В ней два игрока бьют по мячу вперед и назад, как в теннисном матче. На то, чтобы освоить игру, искусственному интеллекту потребовалось всего пять минут. Правда, он часто пропускал мяч. Но скорость обработки информации показала, что его действия были закономерностью, а не случайностью.
Со временем «разумный мозг» стал реже промахиваться, что показало его обучаемость. Правда, только в том случае, если клетки получали обратную связь о своих действиях от ученых.
Бретт Каган надеется, что однажды это исследование поможет в лечении нейродегенеративных заболеваний, таких как деменция.
 Читать по теме:9 народных примет, которые можно объяснить с научной точки зрения
Читать по теме:9 народных примет, которые можно объяснить с научной точки зрения